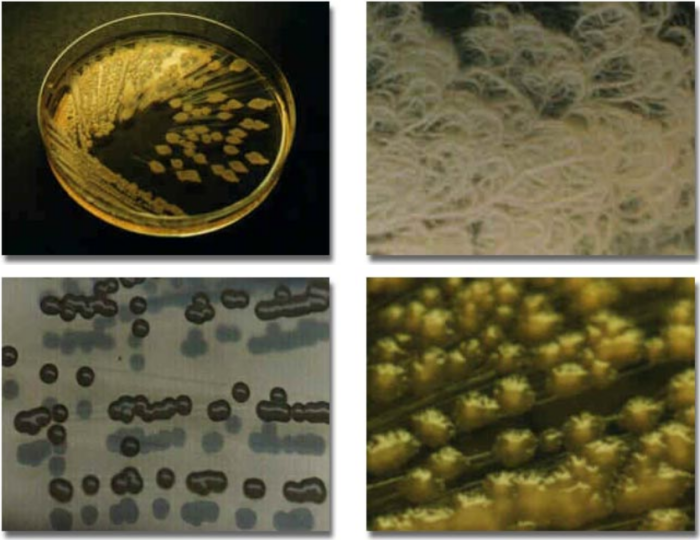

- Home
- Companies
- bioteg Biofilter Systems GmbH
- Products
- Bioteg - Model BT 50 - Biofilter ...
Bioteg - Model BT 50 -Biofilter Material
Bioteg biofilter material bpc BT 50 fine grained, for small biofilters up to 1000 m3 waste air per hour.
The performance of a biofilter depends to a great extent on the filter material. Bioteg takes shredded pine roots as a raw substrate for biofilter material. These pine roots are fractioned several times by sieves and pre-conditioned by a bioteg-developed technique. The surfaces which are available for the microorganism will be doubled by this measure without reducing the long-term stability of the filter material.
Root wood has some advantages in comparison with other filter materials such as the long-term stability. This property results from the high concentration of protection agents (tanning agents) in roots of plants. Plants protect their roots against weathering by this.
Bioteg`s preconditioned root wood is very stable in comparison to other filter materials like peat, heather, cocos or bark. It alters its properties only to a low degree during time (more or less no compaction). This guarantees a long-term functional reliability (appr. 3 to 6 years). The efficiency of biofilters with root wood is better than that of biofilters with alternative materials in all cases investigated by bioteg.
bioteg provides biofilter material in larger amounts as well as in different grain sizes. Delivery is possible at any time after arrangement.